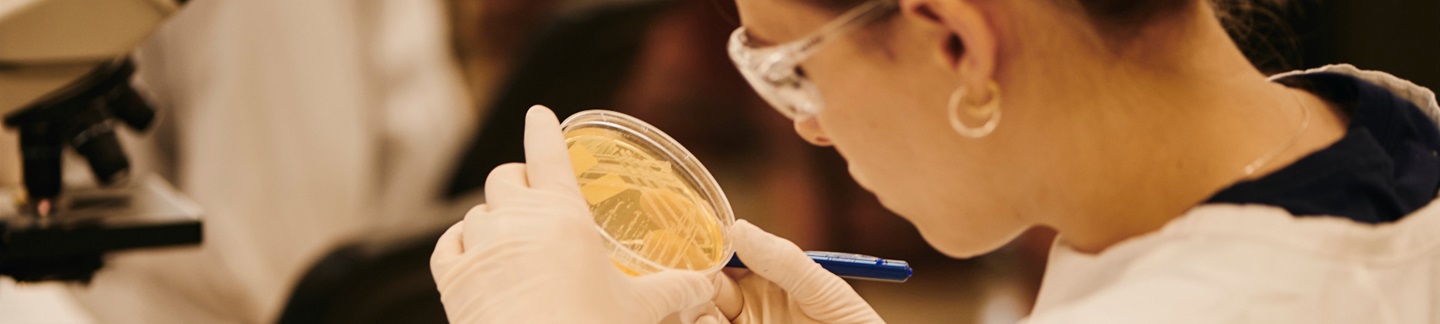

Research excellence?
Internationally renowned research by an award-winning team, creating real-world impact on a global level.
Our UWA researchers are globally recognised for excellence and academic insight into innovative ways to address world challenges.
Our research experts
Meet some of the remarkable people behind UWA's world-leading research.
Jacqueline Batley
Professor
After gaining a BSc (Hons) in Biology from the University of Bristol, I was awarded an MSc from the University of Durham. I undertook my PhD studie...
Hongqi Sun
Professor
Dr. Hongqi Sun is a Professor of Chemistry and an ARC Future Fellow (Level 3) at the School of Molecular Sciences, The University of Western Austra...
Jo McDonald
Professor
Jo McDonald is the Director of the Centre for Rock Art Research + Management at UWA. She has held the Rio Tinto Chair in Rock Art Studies (2012-202...
Find a researcher
Find an expert who can collaborate or partner on your research project. Learn more about the impact our researchers are having across a broad range of areas.
